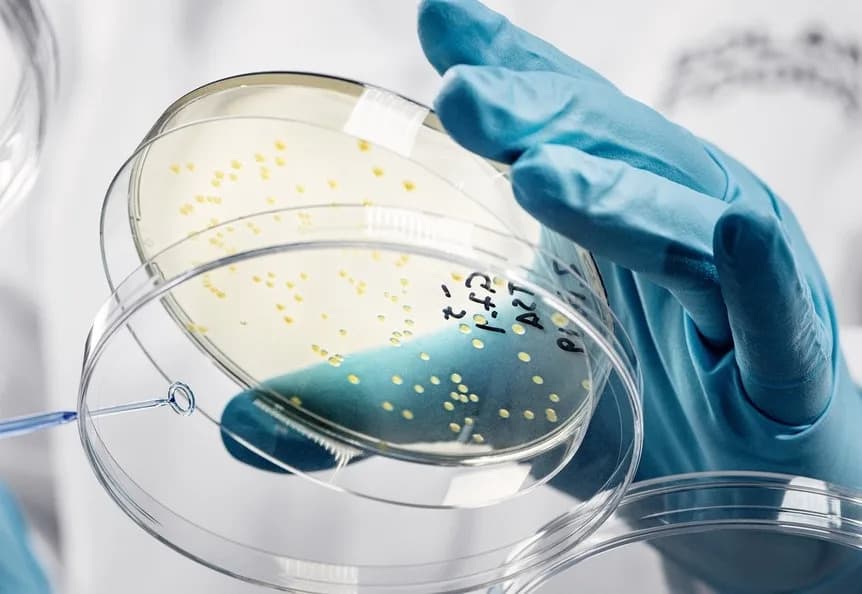
Iz urina do proteina: ESA i Solar Foods testiraju proizvodnju svemirske hrane Solein na ISS‑u

Najvažnije astronomske priče 2025: Asteroid koji je uznemirio svet, prvo privatno uspravno sletanje i novi pogledi na nebo

2025. donela je intenzivnu dinamiku u astronomiji: asteroid 2024 YR4 je privremeno imao procenu rizika od sudara sa Zemljom, ali su kasnije opservacije tu opasnost praktično isključile dok je manji rizik za Mes...